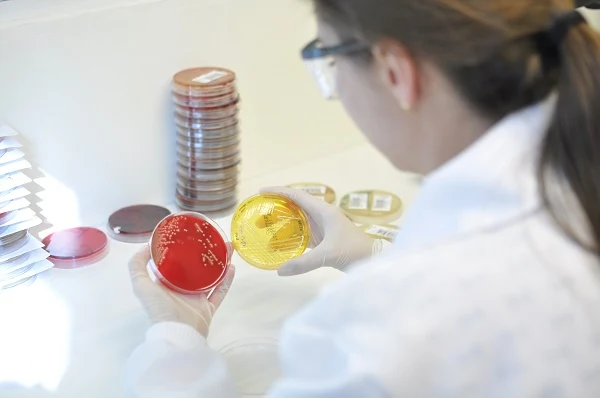

Maior hospital exclusivamente pediátrico do Brasil, Pequeno Príncipe tem foco em casos de alta e média complexidade, em 32 especialidades médicas.
Hospital foi um dos pioneiros a implantar conceito de atendimento humanizado, que inclui acompanhamento educacional, psicológico e atividades culturais.
A Volkswagen do Brasil acaba de renovar o apoio financeiro viabilizado ao Hospital Pequeno Príncipe, por meio da renúncia fiscal. Localizado em Curitiba (PR), é a maior unidade do Brasil exclusivamente pediátrica e referência nacional no atendimento de crianças e adolescentes (0 a 18 anos), com foco em casos de alta e média complexidade, em 32 especialidades médicas, como oncologia pediátrica, cardiologia (inclusive cirurgias em bebês), ortopedia e transplantes.
Com uma história de 96 anos dedicados à saúde, a instituição também conta com o Instituto de Pesquisa Pelé Pequeno Príncipe, cujos estudos também são beneficiados pelo apoio da Volkswagen do Brasil, e as Faculdades Pequeno Príncipe, uma instituição filantrópica. Dessa forma, o Complexo Pequeno Príncipe alia a promoção da saúde, a formação de novos profissionais e o desenvolvimento de métodos que contribuam para a diminuição da mortalidade infantojuvenil.
A Volkswagen do Brasil – que tem uma de suas quatro fábricas em São José dos Pinhais (PR) – mantém esse investimento desde 2009 e é considerada uma das principais parceiras do Hospital Pequeno Príncipe, que foi um dos pioneiros a implementar o conceito de atendimento humanizado, oferecendo também aos pacientes e familiares acompanhamento educacional, psicológico, além de atividades culturais variadas, como pintura e desenho.
“A Volkswagen do Brasil apoia o Hospital Pequeno Príncipe, pois reconhece a importância desse trabalho que ajuda a salvar vidas de crianças e adolescentes. Ao patrocinar a instituição, nossa empresa reafirma seu compromisso com a comunidade e o desenvolvimento sustentável do País”, afirma o diretor de Assuntos Corporativos e Relações com a Imprensa da Volkswagen do Brasil, André Senador.
O apoio ao Hospital Pequeno Príncipe faz parte de um pacote maior de patrocínios da Volkswagen do Brasil, que envolve diversos projetos no País. Entre eles estão iniciativas nas áreas cultural, esportiva, educacional, de entretenimento, desenvolvimento social, preservação ecológica, outros projetos de saúde etc.
“Nós agradecemos muito a contribuição e a confiança da Volkswagen do Brasil em nossa instituição. São seis anos de parceria por meio do Fundo da Infância e da Adolescência (FIA) com investimentos nos nossos diferentes programas que, somados a outros investidores, contribuem para a atualização de equipamentos, aquisição de medicamentos não subsidiados pelo SUS, financiamento para a formação de novos profissionais de saúde e apoio para os familiares que acompanham os pacientes. Temos a capacidade de multiplicar cada real que é investido aqui. Estamos fazendo a diferença juntos e juntos podemos fazer mais”, disse a diretora executiva do Hospital Pequeno Príncipe, Ety Cristina Forte Carneiro.
Sobre o Hospital Pequeno Príncipe
O Hospital Pequeno Príncipe destina cerca de 70% de sua capacidade para o Sistema Único de Saúde (SUS). Com um corpo clínico composto por aproximadamente 300 médicos, o hospital conta com 390 leitos, sendo 62 deles de UTI (pediátrica, neonatal e cirúrgica). Em 2014, o hospital realizou aproximadamente 314 mil atendimentos ambulatoriais, mais de 24 mil internações, 19 mil cirurgias e 565 mil exames.
Na última década, realizou mais de 400 transplantes de órgãos, sendo que no transplante de rins se equipara aos melhores do mundo em sobrevida dos pacientes. Mais de 1.500 médicos pediatras, anestesistas, ortopedistas e cirurgiões pediátricos de todo o País já complementaram sua formação e especialização em estágios e residências médicas no Hospital Pequeno Príncipe.
Faculdades Pequeno Príncipe
Inicialmente concentradas no Hospital, as ações educacionais do Complexo Pequeno Príncipe foram expandidas, culminando, em 2003, com a criação das Faculdades Pequeno Príncipe. As faculdades oferecem os cursos de graduação em Enfermagem, Psicologia, Biomedicina, Farmácia e Medicina, especializações e cursos de mestrado, doutorado e pós-doutorado.
Instituto de Pesquisa Pelé Pequeno Príncipe
O Instituto de Pesquisa Pelé Pequeno Príncipe foi inaugurado em 2006 e tem como padrinho o ex-jogador de futebol Edson Arantes do Nascimento, o Pelé, que também é “Embaixador da Volkswagen”.
O Complexo Pequeno Príncipe é uma organização não governamental mantida pela Associação Hospitalar de Proteção à Infância Dr. Raul Carneiro, entidade sem fins lucrativos que reinveste nas atividades de saúde, ensino e pesquisa todo o resultado obtido. O Hospital Pequeno Príncipe está localizado na rua Desembargador Motta, 1070, Curitiba (PR). Mais informações no site: www.pequenoprincipe.org.br.
Volkswagen do Brasil
Assuntos Corporativos e Relações com a Imprensa
Diretor: André Senador
Renato Acciarto | Tel 11 4347-5060 | renato.acciarto@volkswagen.com.br
Andrea Cipriano | Tel 11 4347-2827 | andrea.cipriano@volkswagen.com.br

Nenhum comentário:
Postar um comentário